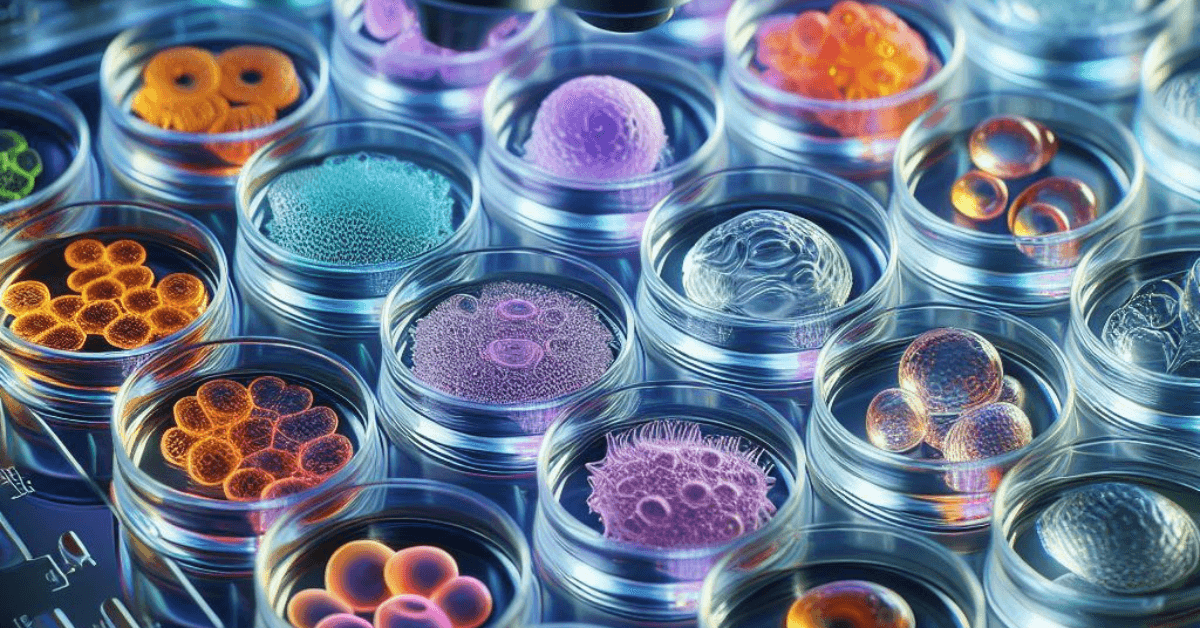

AffiGEN - Your Premier Life Science Supply Chain Partner
Advancing scientific discovery through innovative products and comprehensive supply chain solutions.
Explore by Research Category








Discover Our Popular Products

AffiAB® PLCA Antibody
Cat# AFG-SBT-20243

AffiAB® Mouse Anti-Mouse ASIC1 Monoclonal IgG1
Cat# AFG-STM-1520

AffiELISA® Mikrogen Diagnostik recomWll HPV 16/18/45 ELISA Kit
Cat# AFG-QDB-0209

AffiAB® Anti-Canine Immunoglobulin Antibody
Cat# AFG-QDB-0555

AffiELISA® Mouse Interleukin-19, IL19 ELISA KIT
Cat# AFG-BTL-29814

AffiELISA® General Beta-Endorphin, B-EP ELISA KIT
Cat# AFG-BTL-21125

AffiELISA® Complement Fragment 3a ELISA kit
Cat# AFG-BGE-3635

AffiASSAY® Sialic Acid Assay Kit
Cat# AFG-BOA-078
Explore Our Brands
Who We Are

AffiGEN stands at the forefront of scientific innovation, dedicated to advancing scientific discovery and research across the globe. As a leading multinational company specializing in the development and manufacturing of high-quality scientific research products, we serve university laboratories worldwide with innovative and reliable solutions.
- Comprehensive life science supply chain partner
- High-quality research products for laboratory applications
- Global manufacturing excellence and distribution
- Dedicated technical support and consultation
Featured Products

AffiAB® Envoplakin Antibody
Cat# AFG-FNT-11568

AffiREC® Escherichia coli Relaxosome TraY (traY) Recombinant Protein
Cat# AFG-CUB-1172

AffiELISA® Human Sodium/potassium/calcium exchanger 1, SLC24A1 ELISA Kit
Cat# AFG-NVF-046052
Our Research Facilities

State-of-the-Art Equipment
Our laboratories are equipped with the latest technology for cutting-edge research.

Expert Research Team
Our team of scientists and researchers are dedicated to advancing biotech innovation.
Featured Posters

AffiMEDIUM® for 2D & 3D Cell Culture
View Full Poster
AffiGEL® Matrix Gel for Organoid and Stem Cell Culture
View Full PosterBestsellers

AffiELISA® Human CDK8 ELISA Kit
Cat# AFG-NVF-027332

AffiPEG® Boc-NH-PEG-NH2, 400
Cat# AFG-BPH-0278

AffiPLASMID® pLV3-CMV-SOCS3 (human) -3×FLAG-Puro
Cat# AFG-GNC-21244

AffiAB® XRCC3 (10F1/6), Biotin conjugate, 0.1mg/mL Antibody
Cat# AFG-BTM-17081
Find Us
Contact Information
Address
1700 Drake St,Vancouver,BCV6Z 1Z7,Canada
Phone
(800) 660-1620
info@affigen.com
Business Hours
Monday - Friday: 9:00 AM - 5:00 PM
Saturday - Sunday: Closed
 therapies. The image should depict.webp)

 for genetic disorders. The image should depict siRNA molecules encapsulat.webp)